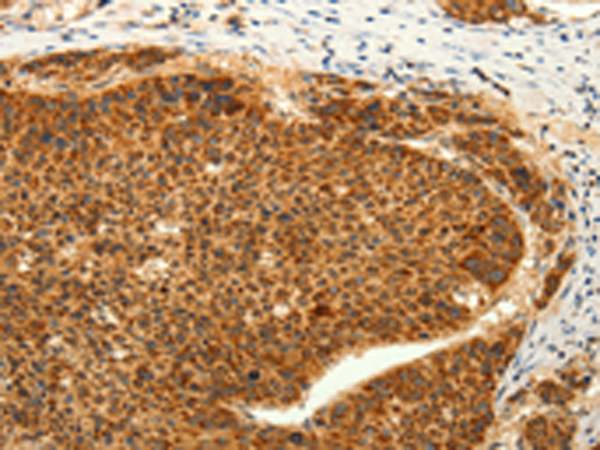

中文名稱: 兔抗TRPC6多克隆抗體
|
Background: |
The protein encoded by this gene forms a receptor-activated calcium channel in the cell membrane. The channel is activated by diacylglycerol and is thought to be under the control of a phosphatidylinositol second messenger system. Activation of this channel occurs independently of protein kinase C and is not triggered by low levels of intracellular calcium. Defects in this gene are a cause of focal segmental glomerulosclerosis 2 (FSGS2). |
|
Applications: |
ELISA, IHC |
|
Name of antibody: |
TRPC6 |
|
Immunogen: |
Synthetic peptide of human TRPC6 |
|
Full name: |
transient receptor potential cation channel, subfamily C, member 6 |
|
Synonyms: |
TRP6; FSGS2 |
|
SwissProt: |
Q9Y210 |
|
ELISA Recommended dilution: |
3000-10000 |
|
IHC positive control: |
Human liver cancer and Human lung cancer |
|
IHC Recommend dilution: |
50-200 |
購物車
幫助
021-54845833/15800441009
